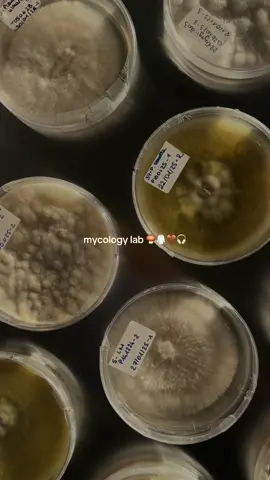

7mod🤩🎩
Region: SA
Wednesday 22 October 2025 08:49:22 GMT
56812
5023
32
1743
Music
Download
Comments
ابو حربـه A👑. :
بلد البلددد😎🥺.
2025-10-22 13:58:26
6
👐🏽 :
الاغنيه
2025-10-22 11:19:11
3
7moD⛷️ :
الغماره يبيلها خط ١٦ وكيس للمراتب 👍🏻
2025-10-23 09:29:31
0
يوسف🤙🏻 :
2025-10-23 13:20:36
0
☪︎ :
الاستوريي
2025-10-22 17:12:05
2
d7o👾. :
ارشيف 2025🥺🥺🥺
2025-10-22 09:27:33
3
R :
ارشيف 2016
2025-10-22 13:46:12
1
X 💔 :
2025-10-22 21:19:29
1
خفوق 🪄. :
حقت النوفي😙👋🏻
2025-10-22 16:38:03
1
R🤦👨🏽🦯 :
@r_144.l عزاه يبو راشد
2025-10-22 11:17:36
2
R :
@Abu Hamoud.
2025-10-22 17:51:40
2
عـعـبود 💙 :
😞✌
2025-10-22 11:27:35
3
ℝ𝕪𝕒𝕟 :
@لوحات زينة ⭐️.
2025-10-22 11:25:37
2
حَجي🐬 :
✔️✔
2025-10-22 16:56:22
1
الحربي🏅 :
هذي حقت النوفي الظاهر التصوير جديد ههههههههههههههههههههههههههههه
2025-10-22 12:22:08
2
To see more videos from user @t.nnn51, please go to the Tikwm
homepage.